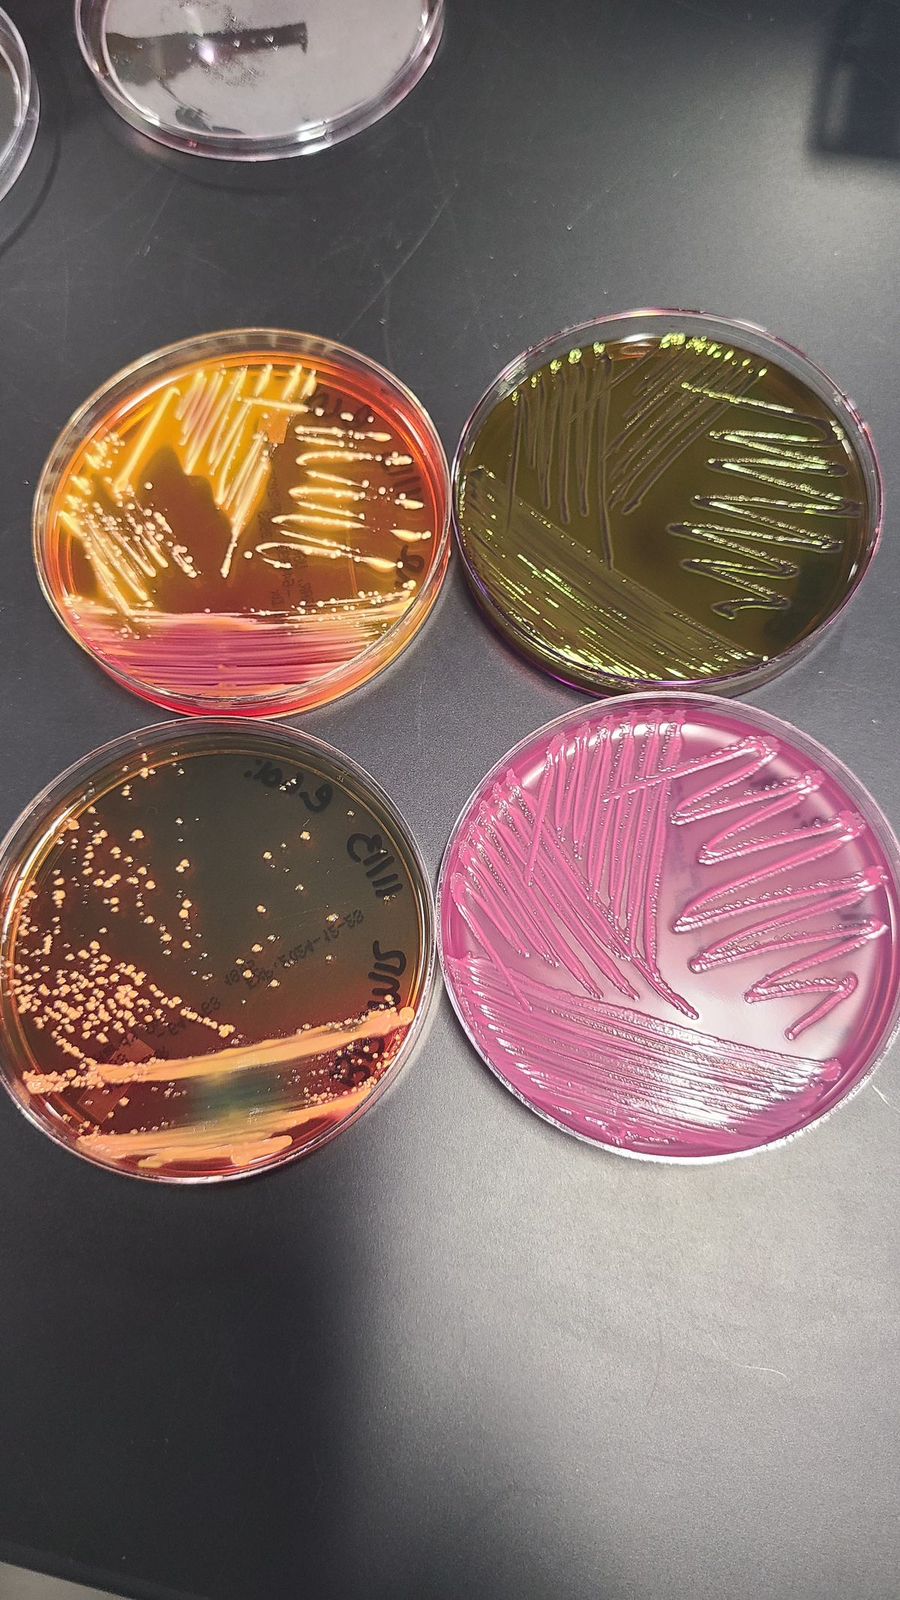

مختبر الفسلجة (Laboratory of Physiology)
يُعد مختبر الفسلجة أحد المختبرات الحيوية لطلبة كلية الصيدلة، حيث يوضح لهم مفهوم التوازن الداخلي للجسم من خلال وظائف الأعضاء. يتم فيه تدريب عملي شامل لطلبة المرحلة الثانية على فحوصات الدم مثل CBC وESR وBlood Groups وBT & CT وغيرها، بالإضافة إلى دراسة وظائف الأعضاء البشرية باستخدام أجهزة حديثة مثل جهاز فحص الجهاز التنفسي Spirometer وجهاز تخطيط القلب ECG، وكذلك قياس العلامات الحيوية مثل ضغط الدم ومستويات السكر في الدم ودرجة حرارة الجسم ومعدل النبض ونسبة الأكسجين في الدم.